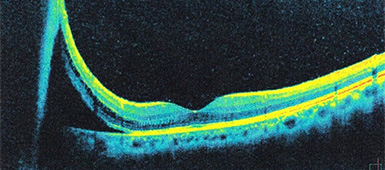
網膜剥離手術前の網膜断層写真
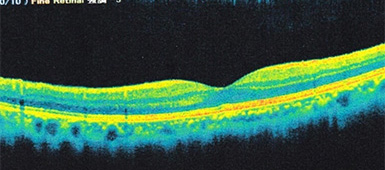
網膜剥離手術前の網膜断層写真
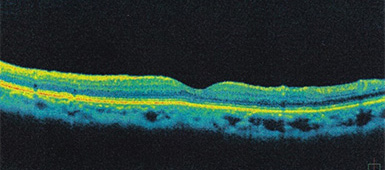
手術後の網膜断層写真
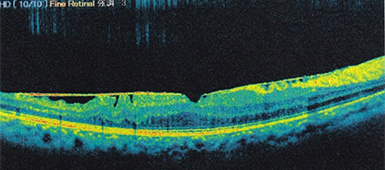
黄手術前の網膜断層写真

硝子体とは眼球の内部を満たしているゼリー状のもので、コラーゲン組織と水分でできています。この硝子体が網膜を引っ張ったり、濁ったりする事で様々な眼球内の病気を引き起こします。
硝子体手術の適応となる病気は、網膜剥離、糖尿病網膜症、硝子体出血、硝子体混濁、黄斑円孔、黄斑前膜などの疾患が適応となります。
手術は局所麻酔で行います。痛みが強い方は痛みを軽減する注射を行います。
手術の方法としては眼球に小さい穴を3か所程開けます。その穴から眼内を照らす照明器具や硝子体カッター、眼内の灌流のための器具を入れ、眼球内の出血や混濁、増殖膜等を取り除きます。疾患により網膜にレーザーを照射したり、網膜剥離や黄斑円孔では、手術の最後に眼球内にガスを入れて網膜を圧迫します。手術時間は疾患によりますが、約30分から1時間程度です。
全て日帰り手術となります。

白内障及び硝子体手術を行う装置です。大学病院などでも使用されている米国のアルコン社製の装置で、従来の手術装置より高い安全性を追求した最新鋭の手術装置です。
手術用の顕微鏡で、白内障や網膜硝子体手術に使用します。
ドイツのカールツアイス社製の眼科用手術顕微鏡で広角眼底観察システムが内蔵されており大学病院でも使われている最新の顕微鏡です。
網膜剥離とは眼球の中にある網膜という膜に穴が開き、そこに液化した硝子体が入り込み、網膜が剥がれてしまう病気です。原因としては加齢により後部硝子体剥離が生じ、それに伴い網膜に穴が開く場合、もしくは若い方ですと網膜格子状変性といった網膜の弱い部位に穴が開き網膜が剥がれる事が多いです。
網膜剥離になると、黒い点など見える飛蚊症、視力の低下や視野の欠損が現れます。網膜剥離は緊急性を要する病気であり、放置しておくと失明につながります。
治療としては、網膜裂孔だけであればレーザー治療を行いますが、網膜が剥がれしまっている場合は手術が必要になります。硝子体手術後は眼内にガスを入れてしばらく網膜を圧迫します。手術時間は1時間程度で、全て日帰り手術となります。
当院では網膜剥離の緊急手術も行っており、今まで数多くの網膜剥離手術を行っております。

網膜の上方に穴があき、そこから液化硝子体が入りこみ網膜が剥がれています。写の白い部分が網膜が剥がれている場所です。

硝子体手術を行い、綺麗に網膜が復位しております。
網膜の断層写真で見ると、網膜下に液化硝子体が入り込み網膜が剥がれているのがよく分かります。
網膜断層写真でみると、網膜下液がなくなり網膜が復位しているのが分かります。
黄斑円孔とは目の中の物を見る中心部、網膜の黄斑部という部位に丸い穴(円孔)が開く病気です。黄斑円孔になると視野の中心部が見えづらくなったり、物が歪んで見えたりします。
原因としては、目の中の硝子体が加齢とともに液状化し、徐々に縮んでいくと、いずれ硝子体が網膜から剥がれます。この現象を後部硝子体剥離といいますが、この後部硝子体剥離が起こるときに硝子体皮質という薄い膜が残り、黄斑部の網膜を強く引っ張ると穴が開き黄斑円孔になります。
治療は硝子体手術で、術後は眼内にガスを入れてしばらく網膜を圧迫します。
手術は1時間程度で、全て日帰り手術となります。

網膜の中心である、黄斑部に小さい円孔が開いています。

黄斑部の円孔は完全に閉じています。

黄斑部が硝子体被膜に引っ張られ、穴が開いているのが分かります。
黄斑部の硝子体被膜が取り除かれ、円孔が綺麗に閉じていることが分かります。
黄斑前膜とは目の中の物を見る中心部、網膜の黄斑部という部位に膜が張る病気です。黄斑前膜になると、物が歪んで見えたり、視力が低下します。
原因としては、目の中の硝子体が加齢とともに液状化し、徐々に縮んでいくと、いずれ硝子体が網膜から剥がれます。この後部硝子体剥離が起こるときに、硝子体皮質という薄い膜が黄斑部の網膜に残り、黄斑前膜を形成します。
治療は硝子体手術で、黄斑部にある膜を剝がします。
手術は1時間程度の日帰り手術となります。

黄斑部周囲に白く写っているのが黄斑前膜です。

黄斑前膜であった白い部分がなくなっているのが分かります。
線状に見えるのが網膜前膜です。

手術前にあった線状のものが取り除かれています。
糖尿病網膜症とは糖尿病の血統コントロールが悪いと網膜の血管にダメージを引き起こし、眼底出血を引き起こします。
放置しておくと、さらに目の中に出血が広がる硝子体出血、網膜剥離、血管新生緑内障になり、最終的には失明につながる怖い病気です。
糖尿病網膜症には進行段階があり、単純網膜症、増殖前網膜症、増殖網膜症へと進行していきます。
単純網膜症から増殖前網膜症ではレーザー光凝固術で治療を行いますが、増殖網膜症で硝子体出血や網膜剥離を起こした場合は硝子体手術が適応になります。
手術時間は網膜症の程度にもよりますが、1時間から1時間半程度です。
全て日帰り手術となります。

糖尿病網膜症による硝子体出血で眼底が見えません。

硝子体手術を行い、出血を取り除き、網膜全域にレーザー光凝固を行っています。
